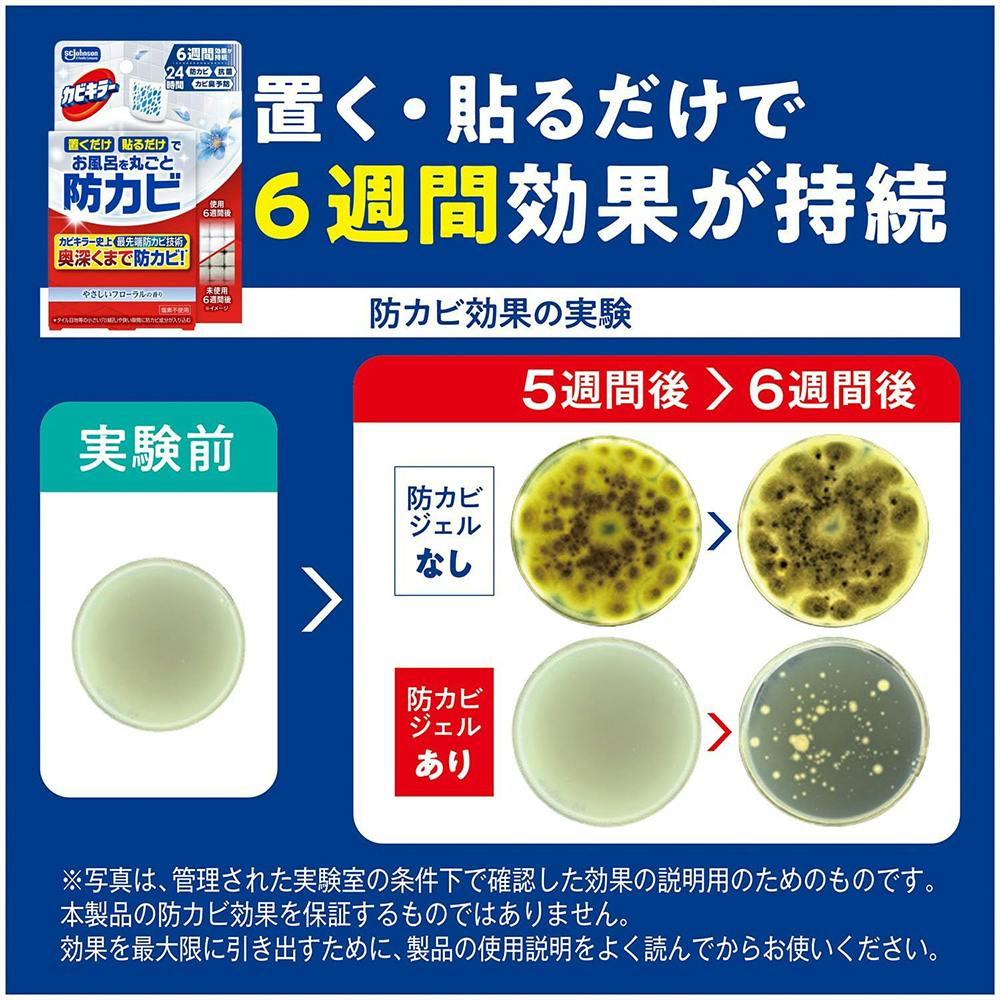

カビキラー お風呂に置くだけ 防カビジェル さわやかなフレッシュガーデンの香り 本体
セール店舗受取で取寄せ可配送で取寄せ可
※商品のデザインや仕様、原産国は予告なく変更となる場合がございます。ご指定はできませんのでご了承ください。
-
-
-
-
-
-
-
-
-
商品の詳細
商品コード
4901609017153
香り
さわやかなフレッシュガーデンの香り
メーカー
ジョンソン株式会社
ブランド
カビキラー
本体/替え
本体
本体サイズ(cm)
幅11.1×奥行3.2×高さ16.4
用途
浴室用カビ防止剤
商品説明
●カビキラー市場最先端防カビ技術で置く深くまで防カビ。●防カビ効果の高いカラシナの種子から抽出したエッセンシャルオイルを選定。●防カビ成分が24時間常に空気中に補充されるため、6週間しっかり効果が持続。●置くだけ・貼るだけの簡単な使用方法。
容量
8ml
原材料
香料、エッセンシャルオイル、色素
使用方法
●箱から本体容器とカートリッジを取り出す。●カートリッジのアルミシールを注意しながらはがす。●アルミシールをはがした面を、本体容器の通気口側に向けてはめ込む。●本体容器を濡れるおそれのない平らな場所に置くか、垂直面に張り付ける。
使用上の注意
●用途以外に使用しない●目に入ると刺激がある●可燃性液体の為、熱源・火花・火器の近くや、高温になる場所の上、直射日光の当たるところ、自動車内などに置かない。子供やペットが触れるところに置かない。
生産国
カートリッジ:中国、本体容器:タイ
-
-
-
-
-
-
-
-
-
-
-
-
-
-
-
-
-
-
商品説明
注意事項
配送地域・送料について
- 北海道、沖縄県、その他各都道府県の離島地域が配送先となる場合は、地域配送料(北海道:500円、沖縄県およびその他離島:1,700円)がかかります。これら以外の配送地域でも、一部商品において追加送料が発生する場合がございます。
- 離島の場合、配送日を指定しても指定日通り届かない場合がございます。
- 別送品は、北海道・沖縄・離島への配送は致しかねます。
- ご入力いただいたお届け先名、住所、電話番号をカインズ以外の出荷元に開示します。プライバシーポリシーの規定に則り厳重に取り扱います。
商品に関する注意事項・説明書
みんなが役に立ったレビュー
レビュー投稿する前に必ず約款をご確認ください。投稿した時点で約款に同意したものとみなします。
-
-
-
-
-
-
-
-
-
-
-
-
-
-
-
-
-
-